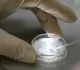
Ученые сообщили об обнаружении вызывающего волчанку вируса

- Общество
- A
Матвиенко назвала блокаду Ленинграда примером духовного мужества
Матвиенко: блокада Ленинграда стала примером духовного мужества жителей города
Председатель Совета Федерации Валентина Матвиенко назвала блокаду Ленинграда не только символом героизма, но и примером истинного духовного мужества, колоссальной нравственной силы жителей и защитников города.
Матвиенко в День памяти жертв блокады Ленинграда 8 сентября направила телеграмму в адрес губернатора Санкт-Петербурга Александра Беглова и жителей города.
"Восьмое сентября 1941 года – день, ставший для нашей страны, нашего любимого города, одним из самых трагичных. Началась блокада Ленинграда. Сколько бы ни прошло лет, мы будем помнить все, что связано со страшными испытаниями, выпавшими на долю ленинградцев... Блокада Ленинграда является не только символом героизма его защитников, но и примером истинного духовного мужества, колоссальной нравственной силы людей, отстоявших город, не позволивших врагу сравнять его с землей, уничтожить его уникальную многовековую культуру", – говорится в телеграмме.
Как отмечается в ней, все подвиги, которые совершили бойцы Ленинградского и Волховского фронтов, жители и защитники города, невозможно перечислить. По словам Матвиенко, каждый день борьбы за Ленинград был подвигом, который остался в наших сердцах и в истории человечества.
"Ленинград одержал величайшую военную и моральную победу над фашизмом. Светлая память погибшим. Вечная слава дорогим ветеранам. Благодаря их отваге и самоотверженности мы понимаем, что в единстве и согласии можно преодолеть все трудности и даже сделать невозможное, если того требует Родина", – заключила Матвиенко.
Блокада Ленинграда, начавшаяся 8 сентября 1941 года, длилась почти 900 дней. Единственный путь - "Дорога жизни" - по которому доставлялось в город продовольствие, был проложен по льду Ладожского озера. Блокада была прорвана 18 января 1943 года, однако до ее полного снятия - 27 января 1944 года - ленинградцам пришлось ждать еще целый год.
Санкт-Петербургский городской суд в октябре 2022 года признал военным преступлением и геноцидом советского народа действия нацистов в период блокады Ленинграда. Собранные прокуратурой города материалы позволяют судить, что численность жертв блокады составила не менее 1 093 842 человек. Ущерб, причиненный нацистами и их пособниками Ленинграду и его жителям, оценивается в 35,3 триллиона рублей по текущему курсу, подсчитали в прокуратуре.

Написать комментарий